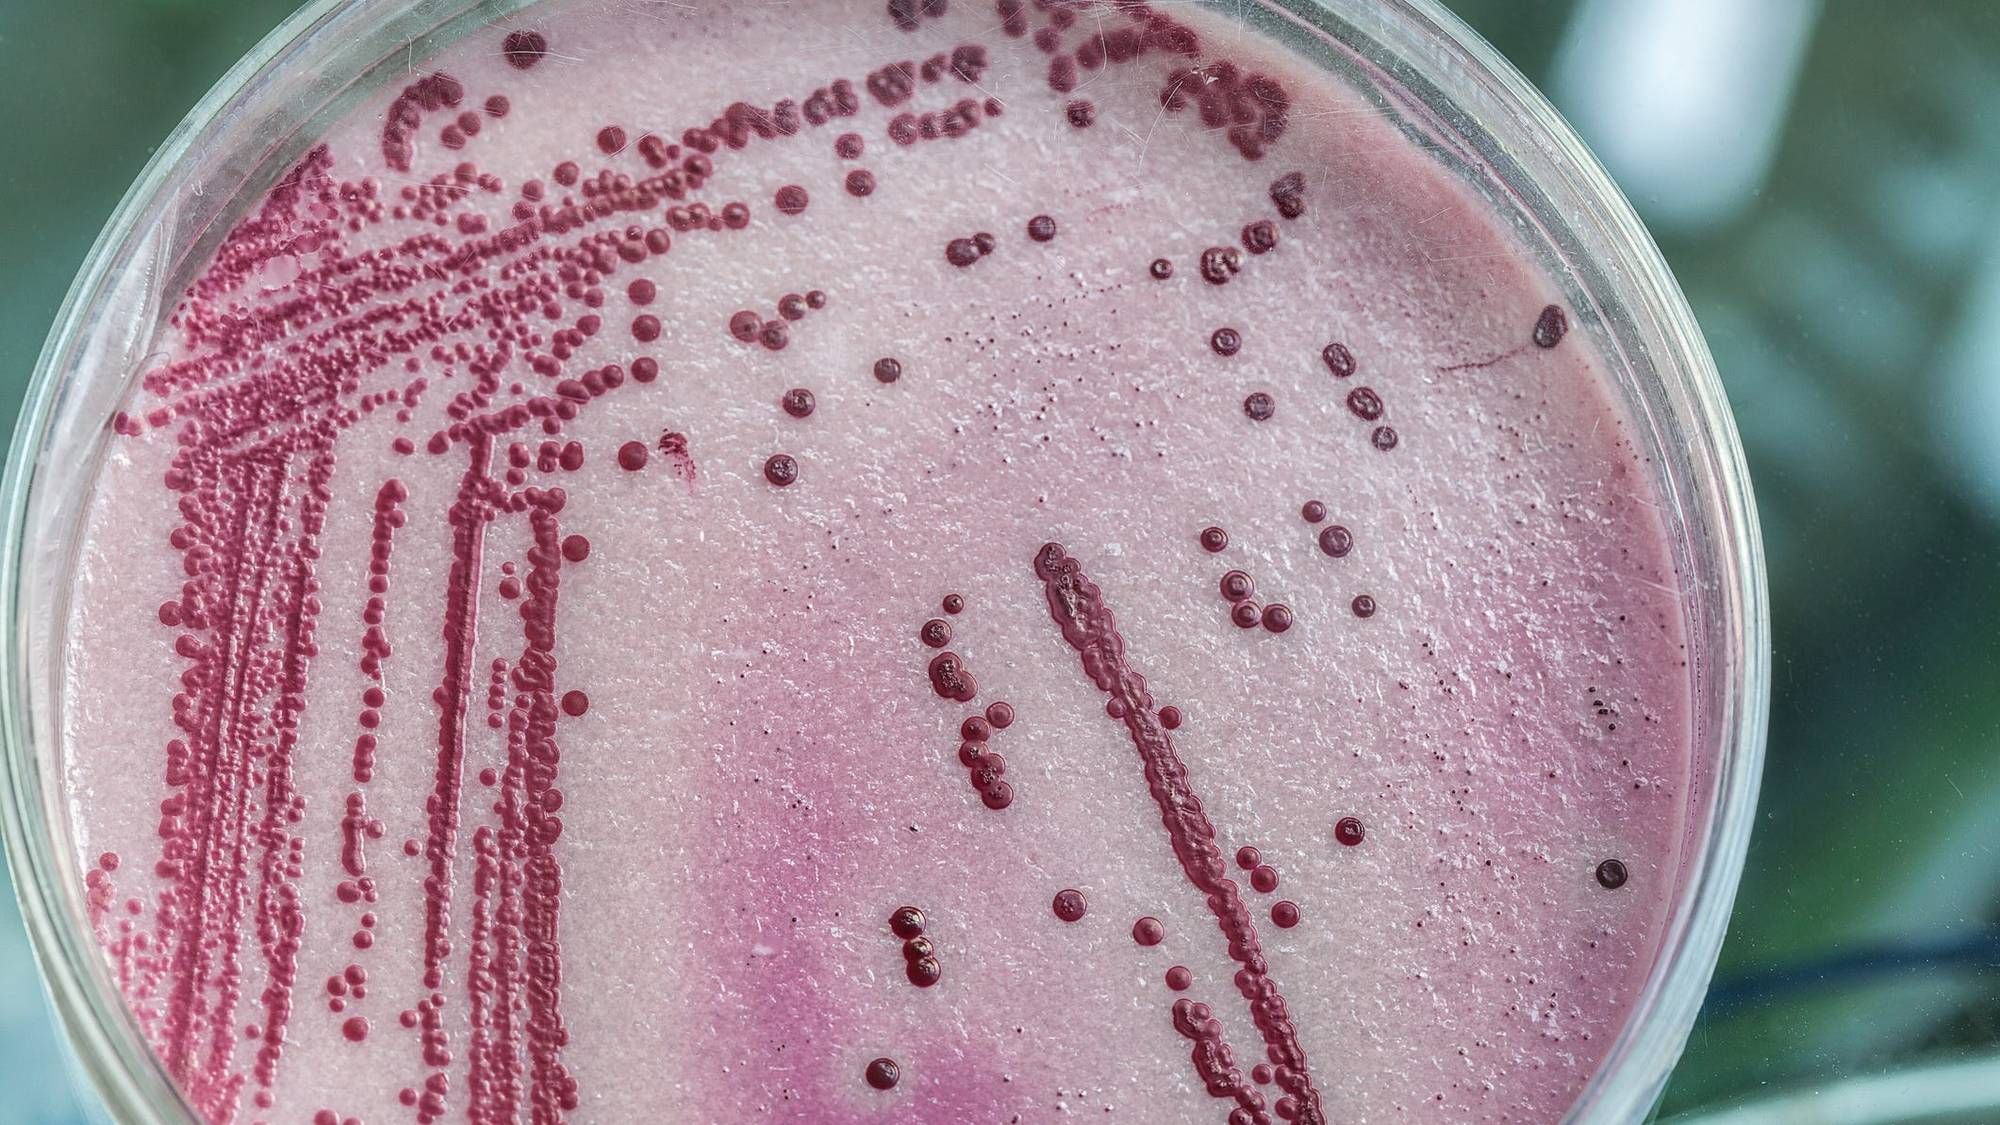

SAN FRANCISCO (KCBS RADIO) – In response to push back from neighbors, Sonoma County officials have approved new rules reigning in vacation rentals.
For more, stream KCBS Radio now.
For some, the new rental rules don't go far enough, for others – mainly rental owners – the rules are too restricted. Sonoma County Supervisor Susan Gorin said Sonoma was one of the first counties to put in comprehensive vacation rental rules more than a decade ago but times have caught up.
"Technology and circumstances are overcoming communities' ability to regulate and protect the quality of our neighborhoods," Gorin said.
Neighbors now complain about large parties, trash, traffic and rentals taking away from the overall housing stock. The new rules set caps on the number of vacation rentals in communities, the number of guests and new rules for parking and noise – aimed at reducing the impacts and discouraging large parties. The quiet hours in neighborhoods are from 9 p.m. to 7 a.m.
"Little by little we made some headway helping out landlords become more responsible, our managers become more responsible and helping our guests understand they are living in a neighborhood and not in a hotel," she explained.
Gorin said the county will consider adding so-called exclusion zones areas where vacation rentals are not allowed.
DOWNLOAD the Audacy App
SIGN UP and follow KCBS Radio
Facebook | Twitter | Instagram